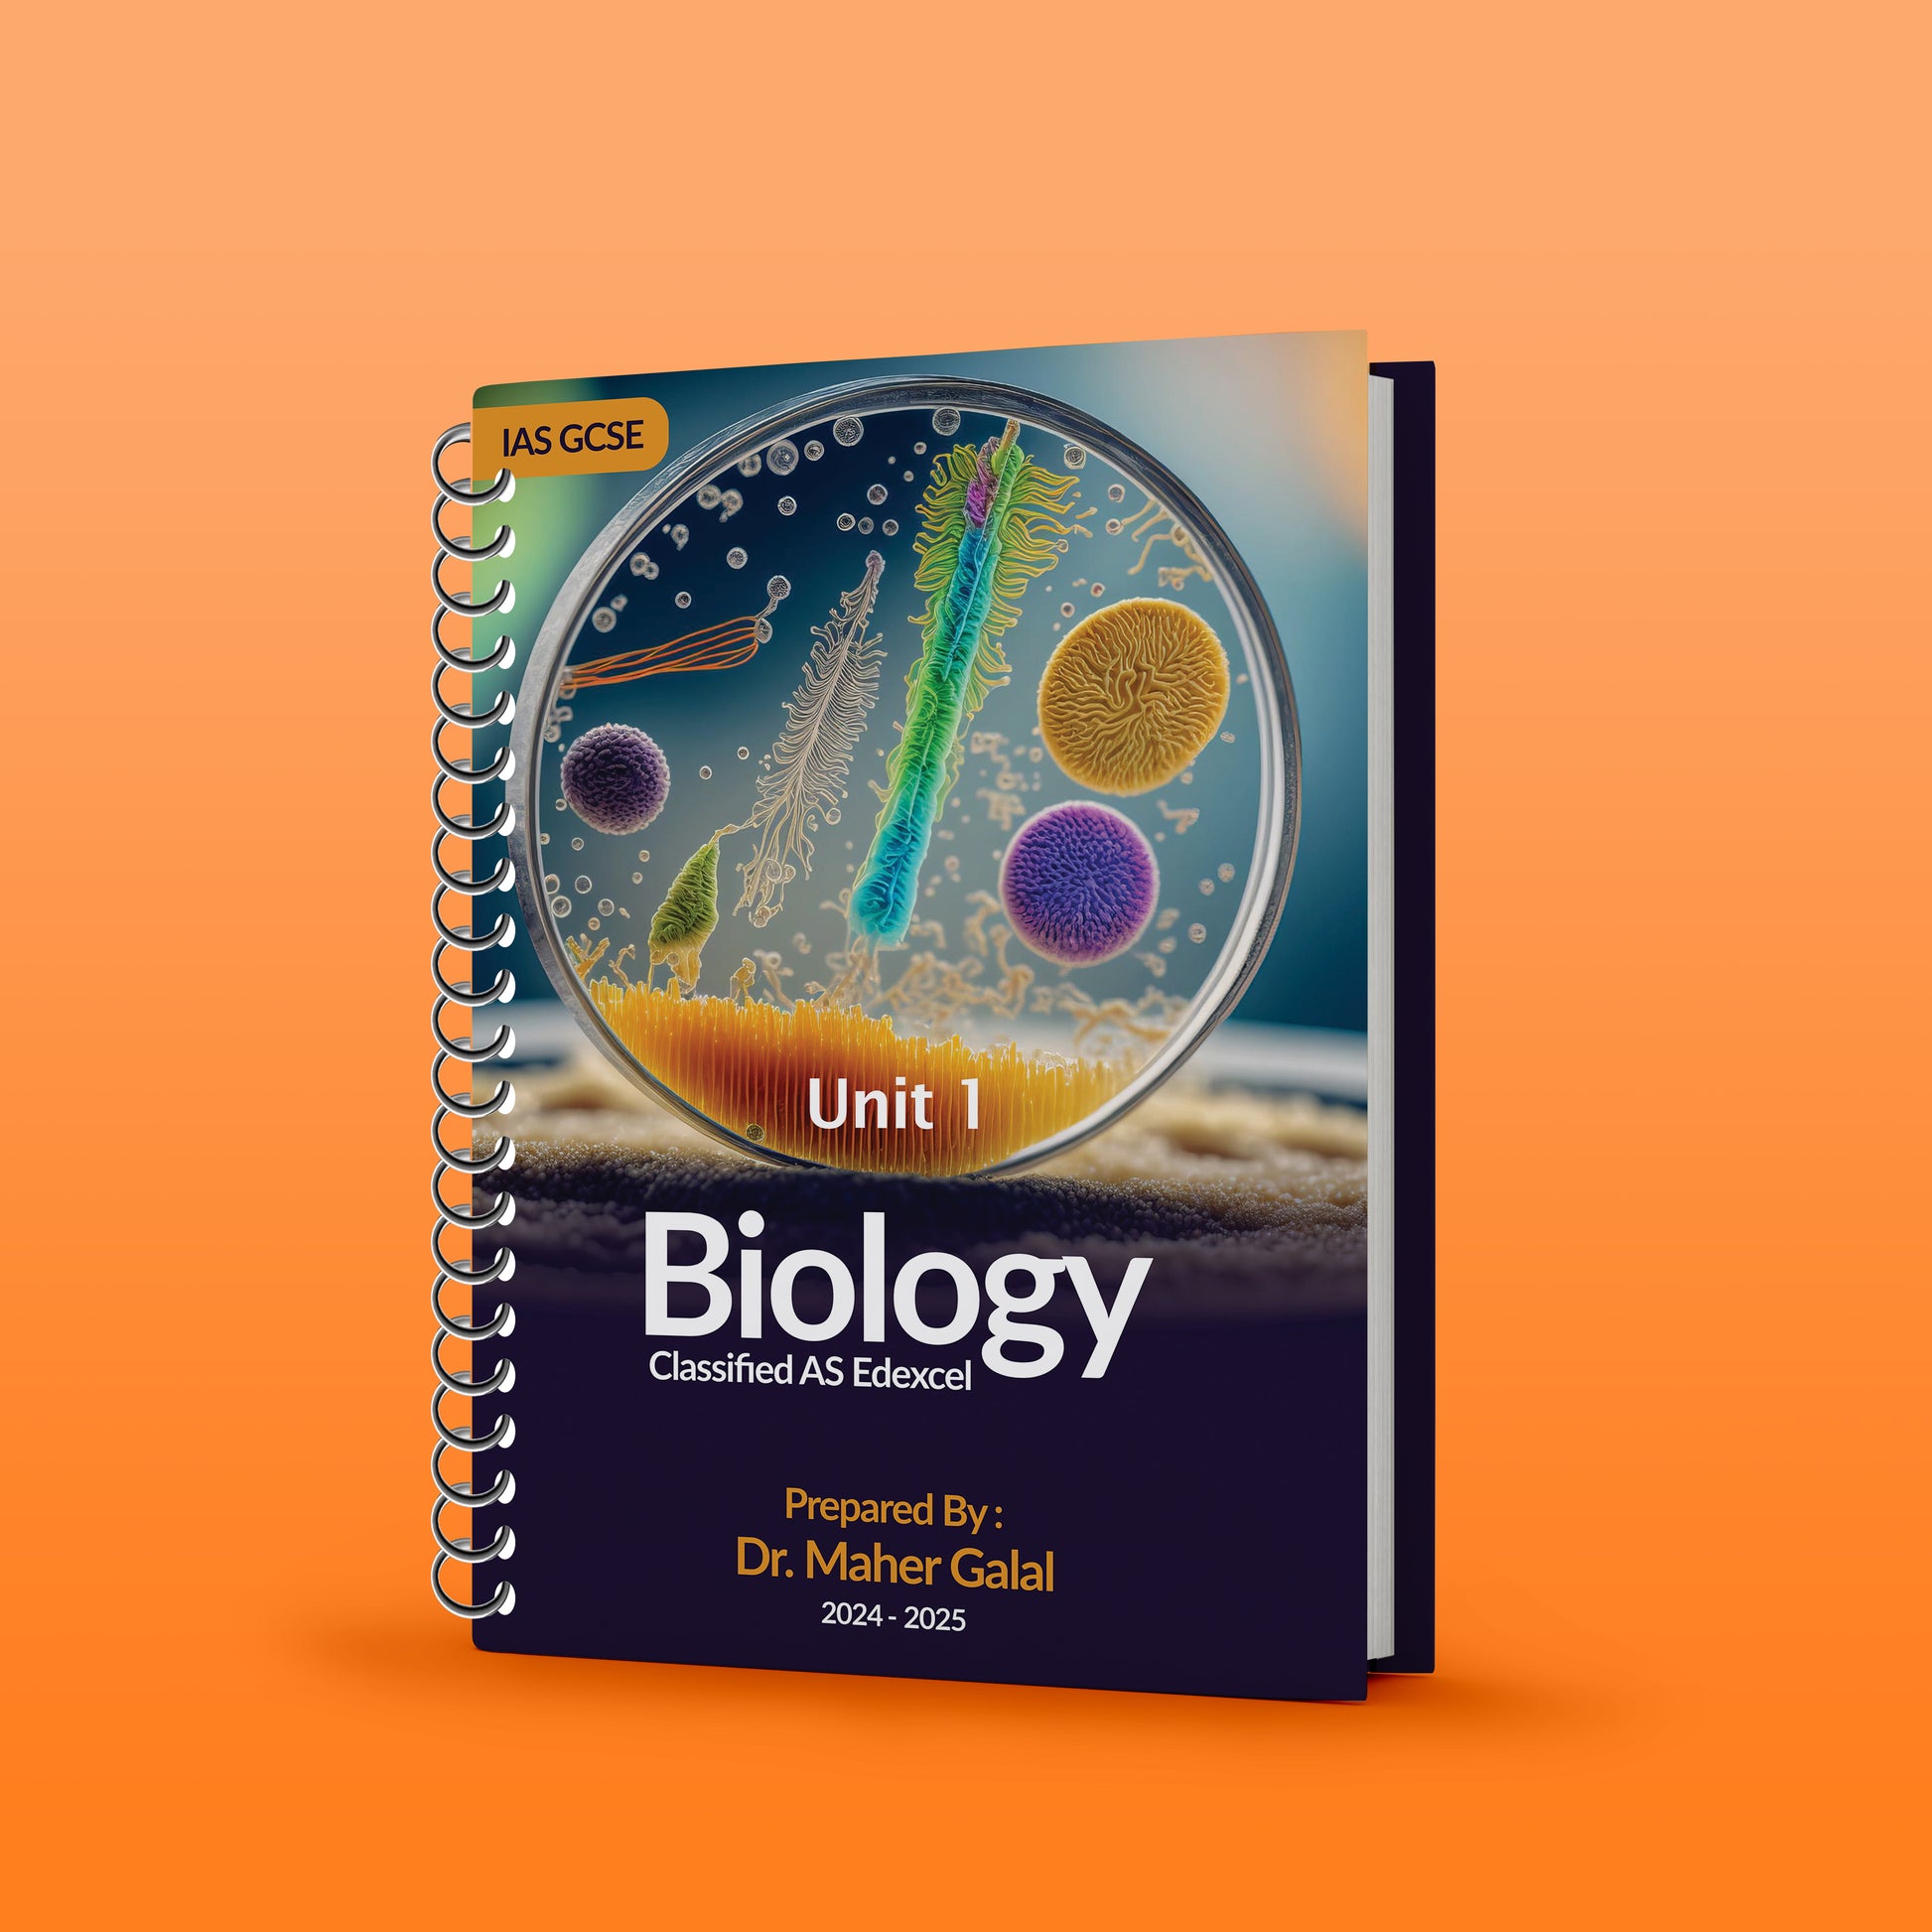

Get the App
Download our mobile app to access soft copies and hard copies of your courses.
1
/
of
1
Edexcel A.S Biology (WBI11) Unit: 1 Classified with mark scheme Maher Galal
Edexcel A.S Biology (WBI11) Unit: 1 Classified with mark scheme Maher Galal
SKU:
Regular price
LE 700.00
Regular price
Sale price
LE 700.00
Unit price
/
per
Couldn't load pickup availability
Share
Get the App
Download our mobile app to access soft copies and hard copies of your courses.
Explore our exam preparation bundles
Discover our extensive collection of classified past papers organized by topic. These classified materials help you practice specific topics and question types, making your exam preparation more focused and effective for Cambridge IGCSE, O Level, A Level, and Checkpoint exams.
Explore Online & Recorded Courses
Looking for interactive learning experiences? Visit EduValley Academy to explore our full range of online and recorded courses. Get access to live sessions, comprehensive video lessons, and personalized instruction from our expert teachers.
-
Cambridge Primary Year 6 Science (0097) Classified With QR Mark Scheme Nada Nafie3 2026
Vendor:Year 6Regular price LE 600.00Regular priceUnit price / perSale price LE 600.00 -
Cambridge Year 7 Science Classified with qr ms Dr. Nada Nafie3 (2026)
Vendor:Year 7Regular price LE 700.00Regular priceUnit price / perSale price LE 700.00 -
Cambridge Pre-IG Biology (0610/0970) Classified - Dr. Omnia Rageh ( 2026 )
Vendor:Pre-IGRegular price LE 1,100.00Regular priceUnit price / perSale price LE 1,100.00 -
Cambridge Pre-IG Biology (0610/0970) Classified Ahmed Wael
Vendor:Pre-IGRegular price LE 800.00Regular priceUnit price / perSale price LE 800.00



